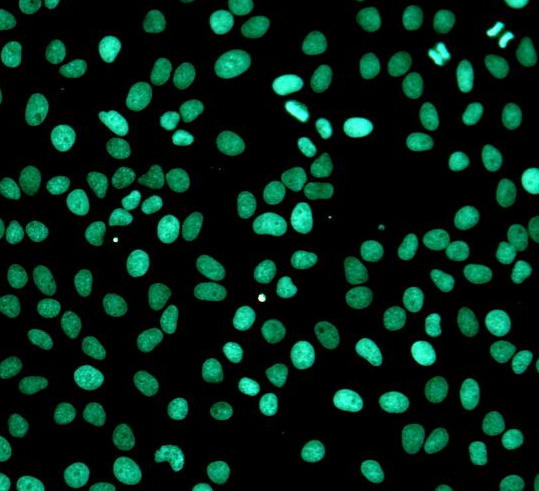
One-step TUNEL.png

AGENT BRAND
品牌專題在細(xì)胞學(xué)研究中,對全面的細(xì)胞狀態(tài)的檢測方法,世界各地的細(xì)胞學(xué)專家在進(jìn)行細(xì)胞狀態(tài)測試時可能會遇到以下問題:
比如:
目前常用的細(xì)胞狀態(tài)檢測指標(biāo)有哪些?
檢測細(xì)胞增殖的方法有哪些?
檢測細(xì)胞凋亡的方法有哪些?
等等。。。
那么我們看看Biogradtech的回答......
Biogradetech提供深受細(xì)胞研究用戶青睞的產(chǎn)品,全面覆蓋細(xì)胞增殖、細(xì)胞毒性、細(xì)胞凋亡、細(xì)胞老化、氧化損傷等方面的檢測應(yīng)用。產(chǎn)品類型包括具有創(chuàng)新理念和獨(dú)特優(yōu)勢的突破性細(xì)胞凋亡和細(xì)胞增殖試劑盒,以及質(zhì)量上乘、性能穩(wěn)定的檢測試劑盒。滿足您不同的實(shí)驗(yàn)需求,助力您的細(xì)胞學(xué)研究事業(yè)。

一、細(xì)胞增殖試驗(yàn)
細(xì)胞增殖導(dǎo)致許多重要的變化,包括DNA合成、細(xì)胞代謝增加和增殖特異性蛋白表達(dá)。基于熒光染色技術(shù),Biogradetech開發(fā)的產(chǎn)品可以直接從DNA水平準(zhǔn)確檢測細(xì)胞增殖狀態(tài),同時還可以通過細(xì)胞代謝水平高通量檢測細(xì)胞增殖狀態(tài)。該試劑盒包含一個專利的增殖陰性對照,是一個完美的解決非標(biāo)準(zhǔn)化的增殖試驗(yàn)結(jié)果。目前主要包括EdU和CCK8兩種常用的檢測方法。

圖1所示 CCK8檢測原理圖
訂購相關(guān)信息:
| 英文名稱 | 中文名稱 | 規(guī)格 | 貨號 |
| EdU Cell Proliferation Kit, for Imaging (Green Fluorescence) | EdU法細(xì)胞增殖成像分析試劑盒(綠色熒光) | 100T | D-AKK2030 |
| EdU Cell Proliferation Kit, for Imaging (Red Fluorescence) | EdU法細(xì)胞增殖成像分析試劑盒(紅色熒光) | 100T | D-AKK2031 |
| Super Sensitivity Cell Counting Kit-8 (CCK-8) | 超敏型細(xì)胞增殖檢測試劑(CCK-8) | 10000T | D-AKE106 |
二、細(xì)胞凋亡檢測
細(xì)胞凋亡是細(xì)胞對環(huán)境的生理和病理刺激信號、環(huán)境條件的變化或?qū)孟⑿該p傷的有序變化作出反應(yīng)的一種死亡過程。細(xì)胞凋亡涉及DNA斷裂、細(xì)胞膜結(jié)構(gòu)、線粒體膜電位和蛋白表達(dá)等一系列形態(tài)學(xué)和分子變化。Biogradetech開發(fā)了一系列用于細(xì)胞凋亡多維分析的試劑盒。
| 類別 | 檢測方法 |
| 形態(tài)學(xué) | 顯微鏡觀察 |
| 細(xì)胞功能 | 線粒體膜電位檢測,膜聯(lián)蛋白V/PI |
| 生化標(biāo)記 | 凋亡分子標(biāo)記檢測,DNA損傷檢測 |
圖2所示 One-step TUNEL Apoptosis Assay Kit (Green Fluorescence)檢測DNase I處理HeLa細(xì)胞24小時的結(jié)果。圖中綠色熒光為TUNEL染色陽性細(xì)胞。
訂購相關(guān)信息:
| 英文名稱 | 中文名稱 | 規(guī)格 | 貨號 |
| One-step TUNEL Apoptosis Assay Kit (Green Fluorescence) | 一步法,TUNEL細(xì)胞凋亡檢測試劑盒(綠色熒光) | 50T | D-AKK2010 |
| One-step TUNEL Apoptosis Assay Kit (Red Fluorescence) | 一步法,TUNEL細(xì)胞凋亡檢測試劑盒(紅色熒光) | 50T | D-AKK2011 |
| Annexin V-AF 488/PI Apoptosis Detection kit | Annexin V-AF 488/PI雙染細(xì)胞凋亡檢測試劑盒 | 50T | D-AKE0002 |
三、細(xì)胞毒性衰老損傷的檢測
除了常見的增殖、凋亡指標(biāo)外,Biogradetech還提供細(xì)胞毒性、衰老、遷移、侵襲、DNA損傷等流行指標(biāo)的檢測產(chǎn)品,深受廣大客戶的喜愛。
| 檢測方法 | 舉例 |
| 細(xì)胞乳酸脫氫酶釋放試驗(yàn) | dehydrogenase (LDH) |
| 線粒體中的酶活性 | CCK8, MTT |
| DNA 損傷 | Comet assay |
訂購相關(guān)信息:
| 英文名稱 | 中文名稱 | 規(guī)格 | 貨號 |
| LDH Cytotoxicity Assay Kit | 細(xì)胞毒性檢測試劑盒(乳酸脫氫酶法) | 480T | D-AKK1030 |
| Senescence β-Galactosidase Staining Kit | 細(xì)胞衰老檢測試劑盒(β-半乳糖苷酶法) | 100T | D-AKE3030 |
| Comet Assay Kit (3-Well Slides) | 彗星法DNA損傷分析試劑盒(3孔載玻片) | 15T/75T | D-AKE3040 |
Biogradetech專注于蛋白質(zhì)組學(xué)和細(xì)胞學(xué),致力于抗體、蛋白質(zhì)、分析試劑和試劑盒的創(chuàng)新和開發(fā),成為生命科學(xué)研發(fā)、藥物發(fā)現(xiàn)等領(lǐng)域的關(guān)鍵推動者。我們?yōu)槟峁┳钍艿鞍踪|(zhì)和免疫學(xué)研究用戶歡迎的產(chǎn)品,從蛋白質(zhì)提取定量等基礎(chǔ)免疫學(xué)產(chǎn)品,到免疫學(xué)實(shí)驗(yàn)用的內(nèi)參標(biāo)記抗體、一抗和二抗。細(xì)胞研究用戶最喜歡的產(chǎn)品,從細(xì)胞狀態(tài)檢測的染料和試劑盒,細(xì)胞器提取試劑盒,細(xì)胞亞結(jié)構(gòu)染色示蹤劑和細(xì)胞代謝檢測產(chǎn)品,到細(xì)胞培養(yǎng)的細(xì)胞因子和蛋白質(zhì)檢測試劑盒,只為幫助您的研究事業(yè)! 作為Biogradetech在中國的區(qū)域代理,艾美捷科技有限公司將為中國客戶提供最全面的Biogradetech以及客戶訂制化服務(wù)。歡迎大家隨時聯(lián)系我們。

微信掃碼在線客服